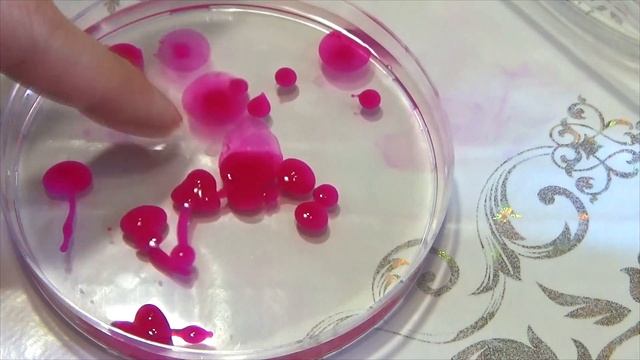
№1 УЖАС!!! Наделали кучу МЕРЗКИХ РАДУЖНЫХ ЧЕРВЯКОВ и ПИЯВОК!!! Увлекательные эксперименты :))) смотреть онлайн

Автор / Канал: Мир Животных HD Страница 14

Строение клетки. Часть 2 | Биология ЕГЭ 2023 | PARTA

Обыкновенная синяя бабочка

Sony's BOKEH-EST Lens?! ?

Как играть с енотом. Часть 1

?? FUNNY CAT MEMES ?? and MOST TRENDING KITTENS 2023 v118|Moments of Cute Animal |You Laugh You Los

Морской лев на пляже ловит рыбу

Семья фазанов

С карелкой на глухаря. Часть 3

Galaga Wars (iOS) 10,918,340 High Score 60p

Как правильно наносить спрей от блох и клещей на животное

Мужчина не смог УБЕЖАТЬ ОТ ТИГРА !!!

колибри? замедленая съёмка
№1 УЖАС!!! Наделали кучу МЕРЗКИХ РАДУЖНЫХ ЧЕРВЯКОВ и ПИЯВОК!!! Увлекательные эксперименты :)))

Полёт ворона.

Неразлучник выкормыш "Птичка"

Змея Сразу Же Пожалела, Что Напала На Дикобраза

красивые картинки и фото сов 2

Коты-воители . Долгохвост

ЧОЙ КВАНГ ДО#CHOI KWANG DO#КОРЕЯ#KOREA# 2015

Цихлазома чернополосая. Первые мальки на 7 месяце жизни!!!

Посылка для собак. TRIOL, Gamma, GiGwi. Лакомства, шампунь, кондиционер, пуходерки, воск для лап

♔VipLeo. Котята каракал нашего питомника. Caracal.

Окуни и верхоплавки зимой на открытой воде

シロイルカショーDelphinapterus leucas show(八景島シーパラダイス)
За каждым успешным каналом стоит личность, идея и сотни часов кропотливого труда. Если вы здесь, значит, автор «Мир Животных HD» уже сумел зацепить ваше внимание своим уникальным стилем или подачей. А мы на RUVIDEO позаботились о том, чтобы вы могли изучить весь архив его работ в максимально комфортных условиях — без лишней суеты и преград.
Почему за работами канала «Мир Животных HD» так интересно наблюдать? Всё просто: это честный контент, который находит отклик в сердцах зрителей. На нашем ресурсе вы можете смотреть онлайн все видео любимого автора бесплатно и в хорошем качестве. Нам важно, чтобы вы видели каждую деталь и слышали каждый нюанс, поэтому мы используем только стабильные плееры из открытых источников Rutube.
Следите за новинками канала, пересматривайте старые шедевры и открывайте для себя новые грани творчества «Мир Животных HD». Мы постоянно обновляем ленту, чтобы у вас под рукой всегда были самые свежие выпуски. Никаких сложных регистраций — только вы и творчество, которое вдохновляет. Приятного вам путешествия по миру авторского контента на RUVIDEO!
Видео взято из открытых источников Rutube. Если вы правообладатель, обратитесь к первоисточнику.